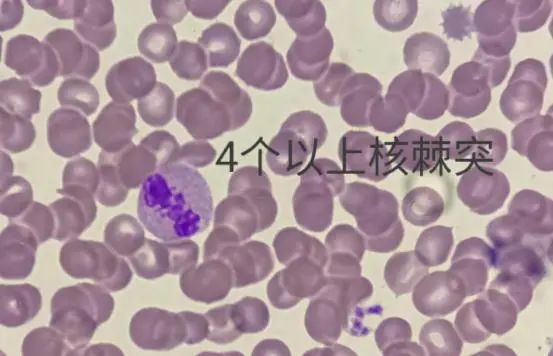
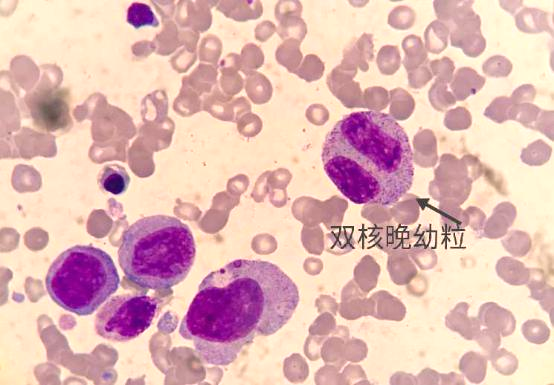
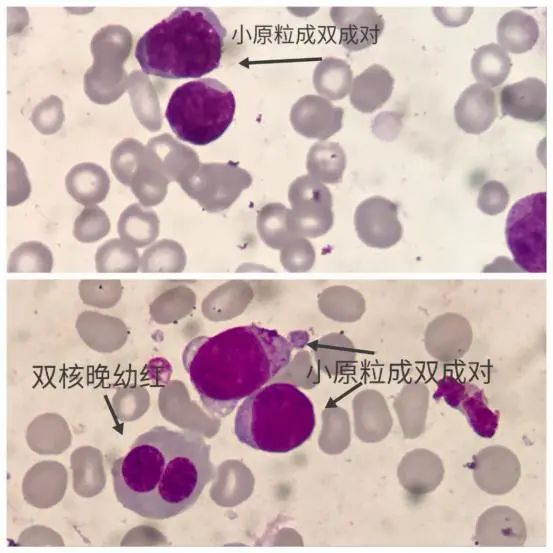
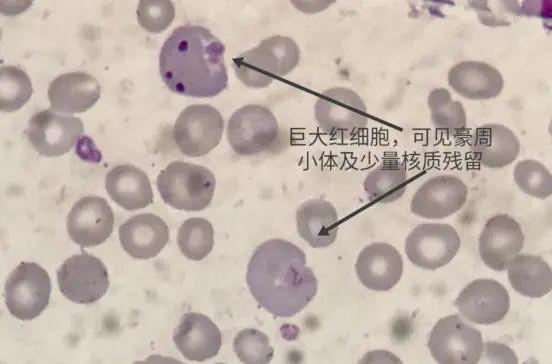
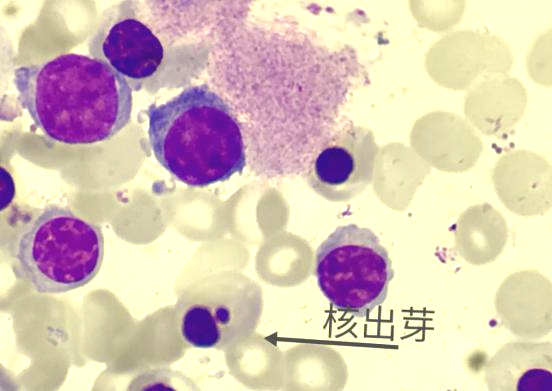

mds是什么病 史上最详细 MDS 异常细胞形态解读笔记
mds是什么病 史上最详细 MDS 异常细胞形态解读笔记
WHO对骨髓增生异常综合征(myelodysplastic syndrome ,MDS)的定义
是一组克隆性造血干细胞疾病,其特征是血细胞减少,髓系细胞一系或多系发育异常,无效造血,以及演变AML的风险增高。
细胞形态学是MDS诊断的基石和灵魂。
MDS形态国际工作组于2016年对MDS的形态学异常文字描述很多,许多初学者对于发育异常细胞和正常细胞的把控有所欠缺,特将粒、红、巨三系形态学发育异常制作一表格并加以详细解读。

造血细胞发育异常(dysplasia)
(所有采图均来自确诊MDS患者)
1 粒细胞生成异常(dysgranulopoiesis,dysG)
A 假性Pelger-Huet畸形
主要是分叶不良。一种是单个核,不分叶,核固缩明显(纯合子有关);分叶减少,两叶为主,呈花生样核、眼镜核、哑铃型核(多与杂合子有关)。与真性Pelger-Huet畸形鉴别:后者整个涂片基本无核分叶现象,核叶1-2个。



B 巨大分叶核中性粒细胞、不规则核多分叶
细胞体积至少达到正常分叶核中性粒细胞大小的2倍,且非生理性的多分叶,胞体大,胞核大,MA时胞体、浆、核均大,可以通俗理解为不和谐的臃肿者与唐朝匀称的胖美人给人的感觉吧。



C 细胞核棒槌小体
一个核上见到4个以上棒槌小体,核突起,且非性染色体相关。
D 异常染色质凝集
染色质聚集成大块状,有清亮区分隔,似凋亡的细胞核,核质变性。中晚幼粒有时显得比较小。

E 双核中晚幼粒:
胞体较大,双核多不对等,核染色质异常分化所致。

F 异常原粒
体积可大可小,部分多颗粒,颗粒<20颗定义为原粒II型,颗粒>20颗但是无可见的高尔基区,定义为原粒III型,和早幼粒细胞进行鉴别。小原粒更多见,且成双成对出现,如影随形。双核原粒多提示恶性,染色体可能为多倍体。偶有畸形核或数量不等的空泡。

G MDS之异常早幼粒细胞
此非M3的异常早幼粒细胞,区别在于前者核形清楚,核染色质细颗粒状,胞浆颗粒大小不一,分布不均匀,有颗粒聚集感,胞质染色蓝色但是有深有浅不匀。M3的异常早幼粒细胞核形蝴蝶或者臀样不规则,可见核出芽,内外浆明显,颗粒覆盖全核或内浆充满颗粒,典型者整体细胞如同一个降落伞外形。

H 胞浆颗粒减少或缺如
胞质颗粒减少至少达到正常中性粒细胞颗粒的2/3。


I 核浆发育失衡
MDS之中幼粒可见内外浆多伴颗粒减少,也可见朝阳红或黄沙洋颗粒,但是不同于M2b的异常中幼粒细胞,后者可见内外浆,胞浆易见空泡,核形多异常,多伴有嗜酸增高,易见Auer小体,下阶段晚幼或成熟粒细胞也可见到Auer小体。



J Auer小体
异常原粒胞浆可见紫红色棒状物。

K 杜勒小体
胞浆类似墨水沾染的嗜碱性物质,实质是发育不良的胞浆成分。
L 假Chediak-Higashi颗粒
紫红色或紫黄色的类圆形颗粒,原始细胞胞浆里体积较大,多圆形规则,大小不等的包涵体样物质。

M 环状核、电风扇样的三叶状核、巨幼样变核


2 红细胞生成异常(dyserythropoiesis,dysE)
A 外周血
成熟红细胞大小不一,巨大红细胞增多(直径>2个正常红细胞直径),可见椭圆形大红细胞、嗜多色性红细胞、点彩红细胞及有核红细胞。

B 核间桥
核与核之间的细丝相连,可以是一个细胞内的两个核之间核丝相连,也可以是两个细胞的核之间细丝相连,如同两个圆石墩之间的独木桥。不是胞间桥,胞浆成分以丝相连,在正常贫血患者骨髓极易见。


C
核出芽:单个芽或多个出芽。
母子核:较多见。
大小核:一个细胞内的两个胞核之间大小不同,如兄弟核,核成熟程度不一样。
核多分叶:核多分叶形似花瓣样畸形。
核碎裂:细胞核固缩引起的核解体,大部分核呈现一个大的椭圆形核结构,旁边是大大小小的碎裂核物质,染色相同。出现率较低。
核形不规则,含H-J小体。

D 多核红
双核:含有两个细胞核的幼红细胞。
多核,尤其奇数核意义大,3核5核等。






E 核膜断裂现象
核的膜不完整,某处如同豁口,中幼红多见。

F 核的幼巨红细胞样改变
体积显著大于正常的幼红细胞,胞核多分叶状,核染色质不均一,有深有浅,复制异常所致,以晚幼红为主,巨中幼红较少见,而MA核浆整体都变大,核染色质烟丝感,中巨幼红多见,有利于二者区别。

G 胞浆空泡
体积显著大于正常的幼红细胞,胞核多分叶状,核染色质不均一,有深有浅,复制异常所致,以晚幼红为主,巨中幼红较少见,而MA核浆整体都变大,核染色质烟丝感,中巨幼红多见,有利于二者区别。




H 束腰核
一个核,两侧中央凹进去犹如哑铃,不是两个核连在一起。

I PAS阳性
糖原聚集,反应红系高度增生和发育异常的恶性本质。


J 环形铁粒幼红细胞
铁粒≥5个以上且围绕核周排列1/3以上,或以任何形式比较有规则的绕核排列者(环状或半环)。(IWGM-MDS)


3 巨核细胞生成异常(dysmegakaryocytopoiesis,dysMK)
A 小巨核
直径多25-40um,细胞面积<800um2,包括淋巴样小巨核和小圆核小巨核。小巨核单核、双核或多核可见。

B 微巨核
即淋巴样小巨核,类圆形,5-8um,细胞核质比大,核染色质浓集,结构不清,无核仁,细胞质极少,边缘不整齐,云雾状,强嗜碱性或含有较多细小紫红色颗粒,常有不规则的毛状或小泡状突起,胞质无颗粒或颗粒极少。外形类似淋巴样小乌龟,核厚实,非轻飘飘的。
这类微巨核属于成熟巨核细胞,对于早期MDS诊断比较重要,是2或4倍体分裂的,说明它越接近干/祖细胞,而正常巨核是8倍体。



C 小圆核巨核
1-3个核,单圆核、双圆核。5q-综合征多见。


D 多圆核巨核
多个小核的大巨核细胞。不管单核或多核,都是核的不分叶,异常状态。

E 巨大或畸形血小板
多直径5um以上,外周血多见。
-

- 粤菜特点,粤菜代表菜有哪些
-
2026-02-01 03:01:31
-

- poem什么意思
-
2026-02-01 02:59:17
-

- qq号被回收了怎么找回来(qq账号被回收了怎么找回)
-
2026-02-01 02:57:02
-

- 国家性质是什么(新中国成立国家性质是什么)
-
2026-02-01 02:54:48
-

- 分手后挽回爱情,正确挽回你得这么做
-
2026-02-01 02:52:34
-

- 安全教育顺口溜,消防安全知识顺口溜
-
2026-02-01 02:50:19
-
- 404什么意思(404什么意思网络语言)
-
2026-01-31 20:44:40
-
- 一颗永流传(砖石广告词一颗永流传)
-
2026-01-31 20:42:26
-

- 9种花卉扦插方法大全!轻松爆满盆!
-
2026-01-31 20:40:11
-
- 彼岸花的经典一句短句(彼岸花的经典一句短句英语)
-
2026-01-31 20:37:57
-
- 浮世绝香(浮世绝香结局是什么)
-
2026-01-31 20:35:43
-

- 翟山鹰(“反诈大师”翟山鹰:诈骗20亿跑路美国,开视频羞辱粉丝)
-
2026-01-31 20:33:28
-

- nasa是什么(nasa是什么牌子羽绒服)
-
2026-01-31 20:31:14
-

- 五险两金是什么(五险两金是什么金)
-
2026-01-31 20:29:00
-

- 国脉互联(国脉互联李凯)
-
2026-01-31 20:26:46
-

- 超好看明信片推荐(三个月300张明信片)
-
2026-01-31 20:24:31
-

- 人体自由基是什么东西,什么是自由基
-
2026-01-31 13:32:23
-

- 美国第一大啤酒品牌(中国第一大啤酒公司)
-
2026-01-31 13:30:09
-

- 百香果外皮能吃,百香果壳可以直接吃吗
-
2026-01-31 13:27:55
-

- 迎驾银星42度零售价格,百年迎驾四星典藏和银星哪个好
-
2026-01-31 13:25:40



 以前很红的歌星卫兰,为何突然销声匿迹了?
以前很红的歌星卫兰,为何突然销声匿迹了? 网传将鄂州并入武汉,城市体量小,又是都市圈副城等都是关键因素
网传将鄂州并入武汉,城市体量小,又是都市圈副城等都是关键因素